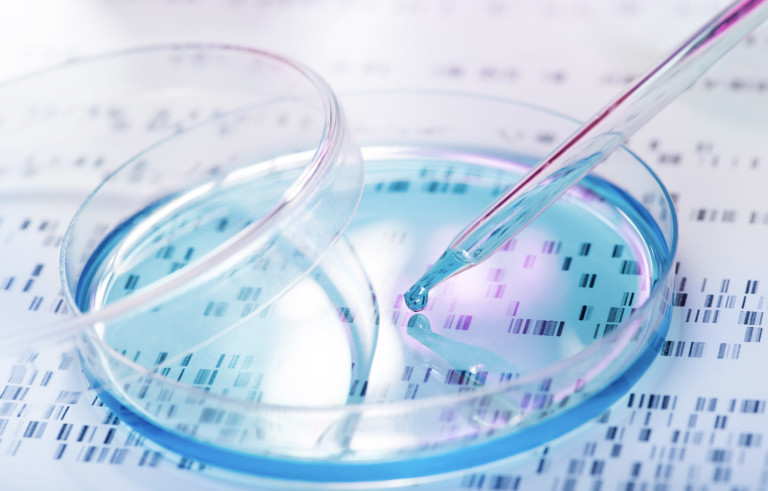
A drug for diarrhea can kill aggressive cancer cells

Article by Danielle Gerhard, PhD. The Scientist - May 4, 2023. Article was originally published on Drug Discovery News. A novel,...
glioblastoma
Image: A Petri dish in a laboratory. Image source: pogonici/Adobe. Article by Mike Wehner. New research suggests that a drug used to...
Article by Anastasia Gorelova St. Louis Post-Dispatch. Veterinary researchers at Mizzou have had such success with a new immunotherapy approach...

DELL
DELL META
META EBAY
EBAY HPE
HPE LUMN
LUMN